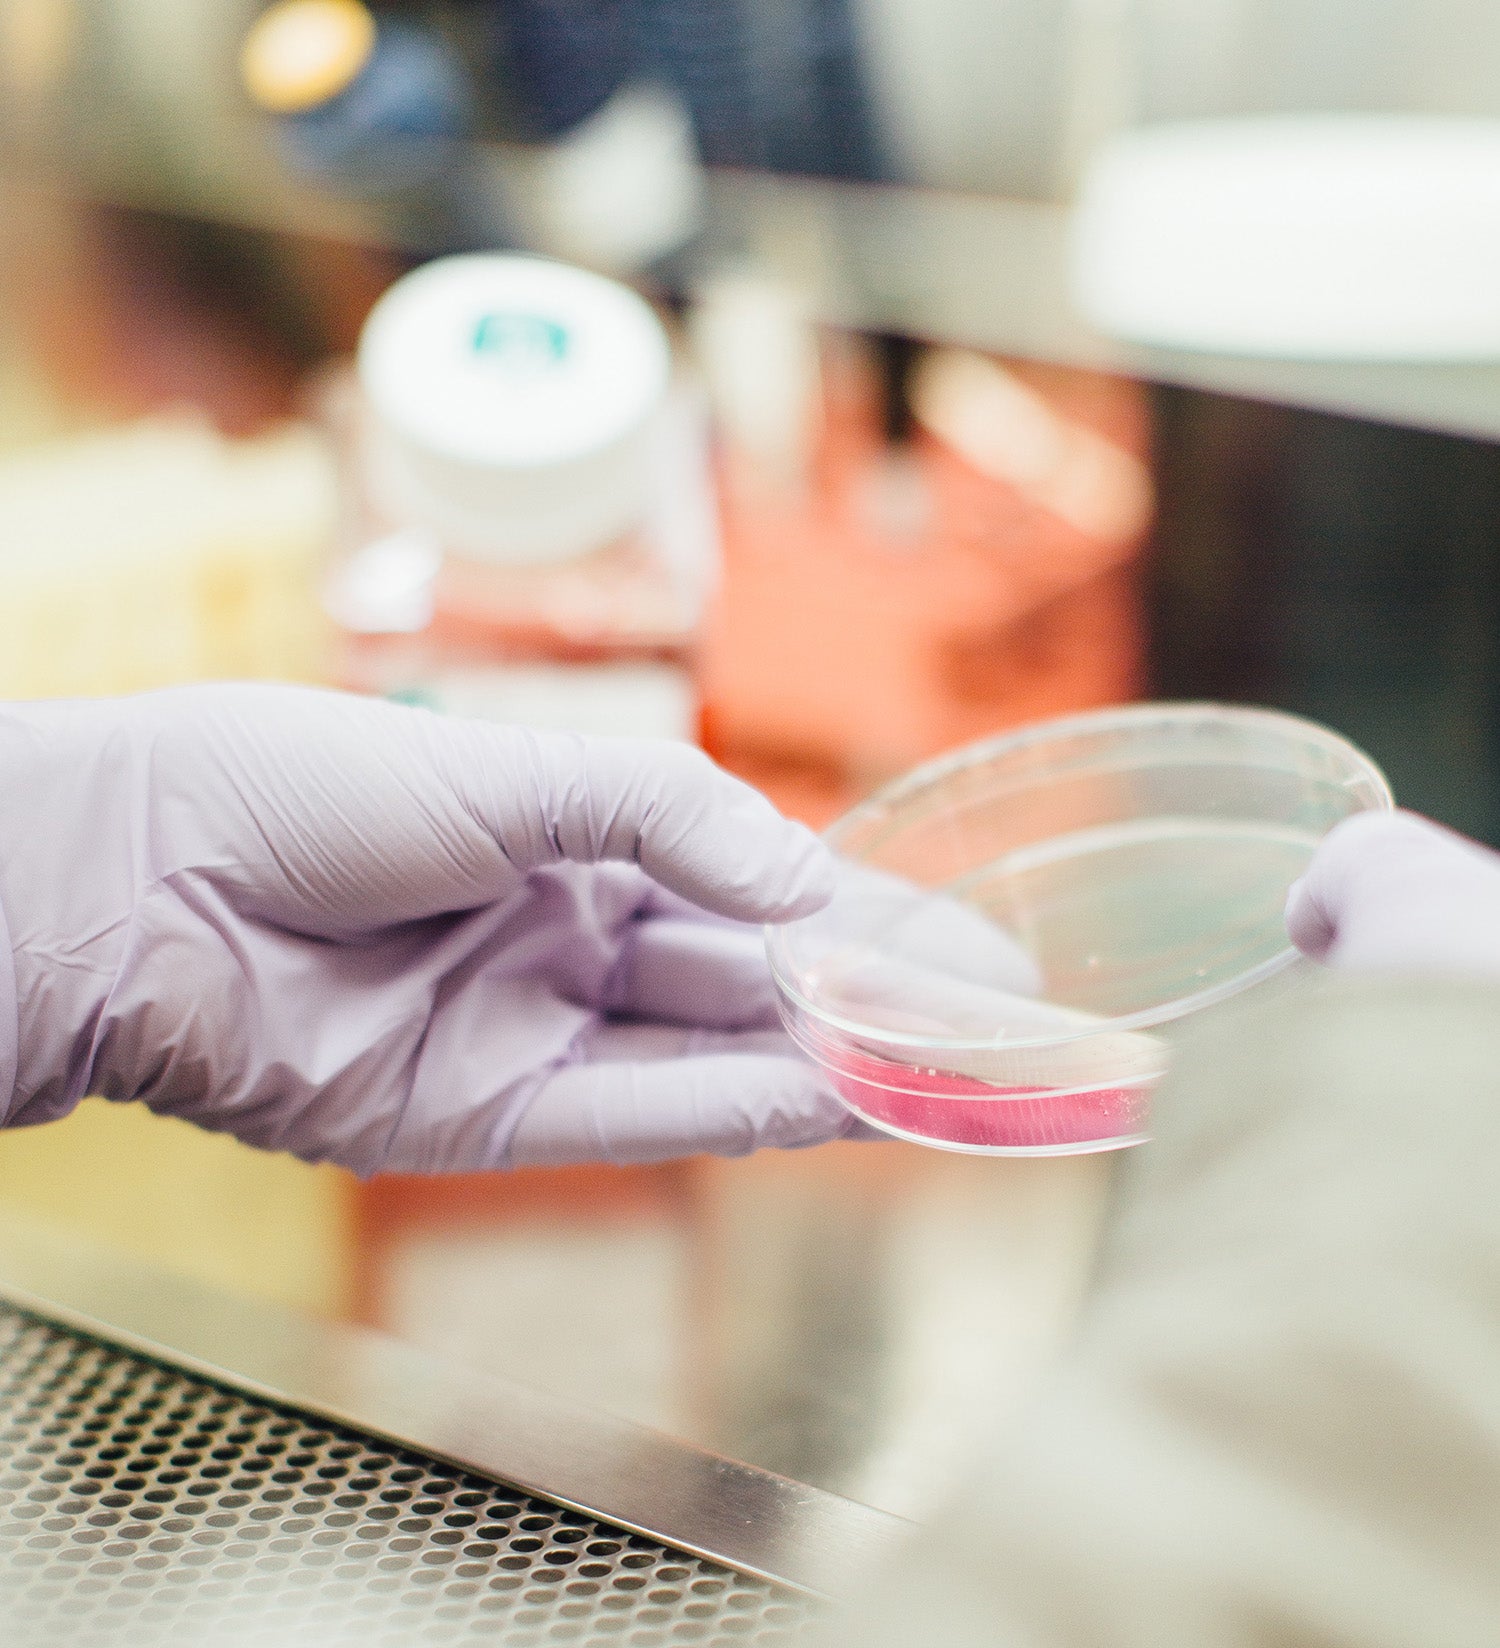

Découvrez l'ensemble de nos métiers

Recherche
La recherche et le développement du GROUPE BERDOUES PARFUMS ET COSMETIQUES s’articulent autour des deux grands axes que sont :
- La parfumerie
- La cosmétique
L’équipe dédiée à ces activités se compose de personnes qualifiées et expérimentées : Ingénieurs et Docteurs en chimie, titulaires de Master en biochimie et de Licence en cosmétique.
A la pointe des tendances et attentive aux nouveautés (veille bibliographique, veille concurrentielle, réunions fournisseurs, salons professionnels), l’équipe R&D est force de propositions et de conseils dans la sélection d’actifs et d’excipients innovants.

Développement
Le département R&D se compose d’une équipe de biologistes et de chimistes d’expérience. Notre savoir-faire s’étend sur les segments des soins (visage et corps), de la parfumerie, de la senteur d’ambiance et du bio.
Le département R&D, à l’écoute des besoins de ses clients propose :
- Des formules clés en main
- Des développements personnalisés et exclusifs
- L’équipe R&D a toujours mis l’accent sur ses fers de lance
Ce qui lui vaut d’être innovante et force de proposition en termes de concept, d’excipients et d’actifs.
Notre laboratoire met au point des formules exclusives, à la fois pour les marques et licences du groupe, ainsi que pour des tiers (laboratoires cosmétiques ou pharmaceutiques).
Sur la base d’un cahier des charges transmis par notre service marketing ou par le client, nos équipes créent des produits sur mesure de grande qualité.
Le développement d’un nouveau produit (au moins 6 mois), s’articule de la façon suivante :
- Soumission d’échantillons pour évaluation sensorielle
- Tests de stabilité physico‐chimique (tests de vieillissement accéléré)
- Tests de compatibilité avec les emballages
- Constitution du Dossier d’Information Produit
Auprès de Laboratoires d’Etudes Cliniques :
- Tests d’innocuité (sous contrôle dermatologique, sensibilisation (hypoallergénicité), phototoxicité,…)
- Tests d’efficacité
- Evaluation de la durabilité
- Tests de stabilité microbiologique (Challenge‐Tests)

Avec plus de 35 ans d’expérience dans le développement de parfums et produits cosmétiques, le laboratoire bénéficie aujourd’hui d’une réelle expertise dans la création de nombreuses formulations conventionnelles ou approuvées BIO (dans le respect du cahier des charges COSMOS) :
- Hygiène et soin du visage, du corps et des cheveux
- Exfoliants
- Traitement du poil (décolorants, dépilatoires)
- Produits bébés
- Eaux de Cologne, eaux de toilette adultes et enfants, eaux de parfum, eaux de senteur sans alcool pour bébés…

Formulation
Fort de plus de 35 ans d’expérience dans le développement de produits de soin, d’hygiène et de parfumerie, le groupe ouvre son savoir‐faire à la sous‐traitance.
L’accompagnement personnalisé de chacun de nos clients dans le respect total de la confidentialité, tant en matière de formulation que dans la constitution des dossiers règlementaires, nous a permis d’établir de façon durable, des relations de confiance privilégiées.
Règlementation
En tant qu’adhérent de la FEBEA et de COSMED, le Groupe maîtrise l’ensemble des exigences réglementaires européennes et internationales liées à la mise sur le marché des produits cosmétiques et peut, à ce titre, aider ses clients dans la constitution des dossiers légaux. Fort d’une culture qualité initiée dans les années 90 selon la norme ISO9002, le GROUPE BERDOUES PARFUMS ET COSMETIQUES répond aujourd’hui parfaitement aux Bonnes Pratiques de Fabrication selon la norme NF EN ISO 22716 (01/2008).
Licencié de l’organisme ECOCERT et adhérant à l’association COSMEBIO, le GROUPE BERDOUES PARFUMS ET COSMETIQUES, fortement engagé dans une démarche environnementale, possède une filière de revalorisation de l’ensemble de ses déchets.

Production
L’entreprise a toujours privilégié l’internalisation de sa production pour l’ensemble de ses marques, afin d’assurer une maîtrise totale de ses processus.
Equipée d’un vaste parc de machines de fabrication et de conditionnement, l’entreprise est capable de répondre à tout type de demande.
Une capacité de production de 30 millions d'unités par an assurée par nos équipes.

Notre outil de production comprend deux salles, dédiées respectivement à la fabrication des parfums et des cosmétiques, avec :
- Un groupe d’osmose inverse, de déminéralisation et de purification de l’eau du réseau, afin de générer une eau déminéralisée de haute qualité.
- Une gestion assistée par ordinateur (ERP) pour les process de fabrication parfums et cosmétiques (pesée et traçabilité des matières premières, enregistrement des ordres de fabrication…).
- Une unité de fabrication de parfums : 4 cuves de fabrication, 4 cuves de glaçage et 1 station de glaçage (1000 litres par heure).
- Une unité de fabrication de cosmétiques : 4 réacteurs de fabrication OLSA (de 250 à 1500Kg).

Nos deux unités de production dédiées au conditionnement des parfums et des produits cosmétiques sont équipées de lignes modulables, capables de répondre à tout type de produit, de packaging et de taille de séries‐techniques.
Quelques exemples de conditionnement :
- Pots, flacons, tubes plastique et aluminium
- Sertissage, vissage, operculage, thermoscellage
- Mise sous étui, encartonnage manuel et automatique
Le GROUPE BERDOUES PARFUMS ET COSMETIQUES assure et garantit une traçabilité totale et une gestion globale, de la prise de commande à l’expédition des produits.

Contrôle qualité
Grâce à son laboratoire d’analyses intégré, le GROUPE BERDOUES PARFUMS ET COSMETIQUES réalise l’ensemble des contrôles physico‐chimiques, analytiques et microbiologiques des matières premières, des produits finis et semi-ouvrés.
De la réception des matières premières et emballages, à l’expédition des produits finis, un contrôle rigoureux est assuré par nos services à tous les stades de la production, selon le même schéma :
Identification ‐ stockage en zone de quarantaine ‐ prélèvement d’échantillons pour contrôle – contrôle au laboratoire – examen des résultats ‐ libération ou blocage par le responsable contrôle qualité.
Le laboratoire de contrôle dispose de l’appareillage nécessaire :
- PH‐mètre, viscosimètre, densimètre, turbidimètre, colorimètre…
- Microscope optique, spectrocolorimètre, RapidOxy et réfractomètre...
Un spécialiste en microbiologie réalise en interne tous les contrôles des matières premières, produits semi‐ouvrés et produits finis.
